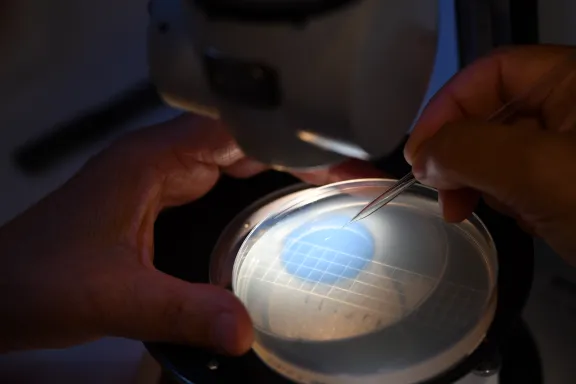

Angela Falciatore Comprendre la vie des organismes photosynthétiques au prisme de la lumière
Angela Falciatore, directrice de l’unité « Physiologie membranaire et moléculaire du chloroplaste » à l’Institut de Biologie Physico-Chimique à Paris
- 2018 • Prix Bettencourt Coups d’élan pour la recherche française

Récompensée du Prix Bettencourt Coups d’élan pour la recherche française 2018, Angela Falciatore, experte mondiale des diatomées, une grande famille d’algues unicellulaires, va prendre la tête d’une unité de recherche parisienne qui étudiera les mécanismes par lesquels la lumière impacte la vie des microalgues et leur photosynthèse.
Les microalgues, de la lumière à la vie
Les microalgues sont injustement méconnues. Ces organismes photosynthétiques d’une incroyable diversité morphologique, génétique et physiologique, se retrouvent dans tous les milieux aquatiques. Ils sont responsables de la moitié de la fixation du CO2 à la surface du globe et également de la moitié de la production de l’oxygène de l’air. À la base de la chaîne alimentaire pour les invertébrés, les poissons, les baleines, elles sont donc le pilier des écosystèmes océaniques. Les chercheurs de l’équipe d’Angela Falciatore souhaitent mieux comprendre la vie de ces organismes photosynthétiques en étudiant les mécanismes activés par la lumière, source d'énergie pour la photosynthèse et source d’information sur les conditions environnementales. Angela Falciatore est soutenue par la Fondation dans son déménagement à l’Institut de Biologie Physico-Chimique où elle prendra dès janvier 2019 la tête de l’unité « Physiologie membranaire et moléculaire du chloroplaste », qui sera renommée « Biologie du chloroplaste et perception de la lumière chez les microalgues ».
Le soutien de la Fondation
Le Prix Coups d’élan pour la recherche française permettra de rénover les espaces de laboratoire nécessaires à l’installation de la nouvelle équipe. De nouveaux incubateurs dédiés à la culture de diverses microalgues seront installés. Les approches multidisciplinaires développées par cette unité de recherche permettront d’acquérir de nouvelles connaissances sur les processus biologiques influencés par la lumière tels que la photosynthèse, les rythmes biologiques ou la photoperception, et leurs conséquences sur la physiologie des microalgues. Ce savoir est fondamental pour appréhender les conséquences des changements environnementaux sur les écosystèmes aquatiques. De nouvelles stratégies pourront être mises en place pour optimiser la production de biomasse et répondre aux demandes en énergie et en nourriture de notre société.
Angela Falciatore en quelques mots
Les diatomées sont les compagnes de laboratoire d’Angela Falciatore. Si petites qu’une vingtaine d’entre-elles pourraient s’aligner sur la largeur d’un cheveu humain, ces microalgues marines comptabilisent pourtant chaque année près de 20 % de la production mondiale d’oxygène.
Au cours de son doctorat, Angela Falciatore a contribué à établir un système de transformation génétique pour les diatomées, ouvrant ainsi la voie à l'étude moléculaire de leurs mécanismes adaptatifs aux changements des conditions environnementales. Son premier post-doctorat lui a apporté des compétences complémentaires sur la photobiologie et la signalisation entre chloroplaste et noyau. Son second post-doctorat la ramène à Naples et aux diatomées.
En développant les outils et ressources génétiques nécessaires pour aborder la biologie moléculaire des diatomées, Angela Falciatore en a fait un organisme modèle attractif. Ses travaux conduits au sein du Laboratoire de Biologie Computationnelle et Quantitative à l’Institut de Biologie Paris Seine ont permis d'identifier des photorécepteurs aux propriétés nouvelles et de mieux comprendre comment les diatomées réussissent à maximiser leur capture d’énergie lumineuse et leur photoprotection dans un environnement extrêmement variable.

Prix Bettencourt Coups d’élan pour la recherche française
Le Prix Coups d’élan pour la recherche française a été créé par la Fondation en 2000, il a récompensé 78 laboratoires français et plus de 900 chercheurs ont bénéficié de ce prix. Jusqu'en 2021, ce prix était attribué chaque année à quatre équipes de recherche, relevant de l’Inserm et de l’Institut des sciences biologiques du CNRS. La dotation du prix était de 250 000 euros par laboratoire lauréat.
Tous les lauréats du prix






